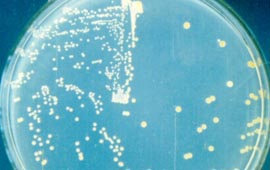
膿皰病

病理概述
 膿皰病--膿痂
膿皰病--膿痂膿皰病是常見症狀,是一種高度傳染性的細菌性皮膚感染,可以出現在身體的任何部位,但常常攻擊身體暴露部位。兒童易在面部患此病,特別是口鼻周圍,有時也可以在臂或腿部。受累部位呈小片狀,約有硬幣大小,開始時是小水皰然後水泡破裂,露出紅色、潮濕的創面,數天后感染部位被顆粒狀、金黃色的痴覆蓋,並不斷向周圍蔓延。
本病的皮損特點為水皰、膿皰及膿痂。表觀如下:初起皮膚上出現淺在的水皰,水皰迅速變成膿皰,有癢感,周圍有炎性紅暈包繞、皰壁薄而易破。破後皰面糜爛,流水浸淫,向四周蔓延,膿皰乾後結成灰黃或蜜黃色厚痂,痂皮脫落後不留疤痕,遺留暫時的色素沉著。本病皮損附近的淋巴結可見腫大。
病症分型
膿皰病分為兩型
膿皰病--切片
膿皰病--切片1、大皰型膿皰病。
由金黃色葡萄球菌引起,初起為粟粒大水皰,迅速增大到花生米大或更大些。開始水皰內容清澈,約1日後,皰液變渾,膿汁沉於皰底,淺層液體仍清亮,呈半月形的積膿現象,是為本型的特徵之一。皰破後成為糜爛面,其上有膿痂。其周圍可發生新的水皰。皮損好發於面部及四肢等露出部位。病理變化為表皮角質層下膿皰,皰內可見多數嗜中性細胞。
2、膿痂性膿皰病。
由溶血性鏈球菌或溶血性鏈球菌與金黃色葡萄球菌混合感染所致。在紅斑的基礎上發生水皰,迅速變為膿皰,皰易破而結成密黃色厚痂,並不斷向四周擴展。好發於面部、口周、鼻孔周圍以及四肢外露部位。病理變化同大皰型。此型可伴發急性腎小球腎炎。新生兒膿皰病屬此型。
病因病理
 膿皰病--感染
膿皰病--感染主要為凝固酶陽性的金黃葡萄球菌或乙型溶血性鏈球菌,也可二者混合感染。促使化膿球菌侵入機體產生本病的因素:一、原存在某些瘙癢性皮膚病,如濕疹,蟲咬皮炎,外傷等,使皮膚損傷,細菌由此侵入,二、天氣炎熱、出汗、使皮膚浸漬或不潔,三、長期套用皮質類固醇激素,使免疫力下降,四、嬰幼兒皮膚薄嫩、免疫功能發育不全.
膿皰病是由鏈球菌或金黃色葡萄球菌引起的感染。這些細菌到處存在——在不乾淨的浴室內,變質的食物中,甚至在我們的體內。皮膚有傷口的兒童,在不乾淨的浴缸或浴盆內洗澡,就有可能患上膿皰病。使用膿皰病人用過的毛巾或肥皂,也會感染此病。其他與皮膚有關疾病,如體虱、真菌或鏈球菌感染、燙傷或各種皮炎,也容易合併膿皰病。
絕大多數病人是通過身體接觸或共用毛巾、衣服、床及其他用品傳染此病的。由於兒童活動時會有大量身體的接觸,所以兒童很易患此病,並且成為傳播者。大量出汗、營養不良及不良衛生習慣,會加重膿皰病病情。
病理症狀
 膿皰病--膿皰
膿皰病--膿皰先是出現小紅斑或小水皰,迅即水皰會逐漸增大並變為膿皰,邊界清楚,有炎性紅暈。膿皰為花生米或蠶豆大小,皰液上部清,下部黃白渾濁,呈典型的半月形積膿現象;破後會露出紅色糜爛面,黃水淋漓,頃刻沿開。泡液乾後結黃色膿痂、黃黑色膿血痂或蜜黃色厚痂,有的中央結痂而邊緣擴展形成新起膿皰,呈環狀或回狀,脫痂後癒合且不留疤痕,有輕重不一的瘙癢。一般無全身症狀,但附近淋巴結常腫大,有的可並發濕疹樣病變、急性腎炎或敗血症。
新生兒抵抗力差,患此病可危及生命。分熱毒型和濕熱型。熱毒型:夏季發病,肌膚水皰或膿皰,四周繞以紅暈,膿皰潰破溢膿,結痂,鄰近淋巴結腫。濕熱型:夏秋季發病,肌膚水皰、大皰,四周紅暈,皰破脂水淋漓,浸淫成片,癢痛相兼,或見發熱,口渴,浸淫成片,納呆,舌苔黃膩,脈濡數。痛,伴發熱,溲赤便乾,口渴,舌紅苔黃,脈數等。
1開始是一小片小水皰,數小時後破裂,表皮脫落,形成紅色不斷有滲出液流出的創面。主要出現在面部,也可見於手、足暴露的部位。
2數日後,局部可形成金黃色或棕黃色的痴,但感染仍可向四周擴散。出現以下情況應去就醫
3開始治療後48小時,面部疼痛仍未消失。膿瘡病的感染需要馬上進行治療。
4如果出現很癢的、小的、含有膿液的潰瘍,上面覆有棕黑色痴,這可能是另一種膿疤病的潰瘍型——深膿瘡(臁瘡),會向皮膚深部穿透。不及時治療,可能形成瘢痕和皮膚色素沉著。
5膿瘡病的症狀在嬰兒身上出現。嬰兒任何持續的皮膚病變均需馬上就診。
6患有膿瘡病的兒童出現噁心、頭痛、尿少、面部及四肢浮腫。這些是腎小球腎炎的徵象,一種由細菌毒素引起的腎病。
7注意:由膿皰病導致的膿瘡可能會被誤診為一種由病毒感染導致的瘡疹。膿皰病發展較快,但決不在口腔內造成病損,並且很少局限在身體的一個部位。如果有疑問,可以讓專門的醫生作出準確診斷。
臨床表現
 病理切片
病理切片一、大皰型膿皰病:多發生於2-8歲兒童,好發於暴露部位,如頭面、四肢,也可波及全身,初為紅斑或水皰,迅即變為膿皰,米粒至黃豆大,周圍有紅暈,皰壁鬆弛,皰內膿汁沉積於皰底,上部為透明液體,形成半月形,皰膜破裂後露出糜爛面,乾燥後形成蜜黃色膿痂,自覺瘙癢,故而搔抓後易自我傳染,向周圍蔓延。
二、膿痂性膿皰病:在紅斑基礎上出現水皰,迅即轉為膿
根據典型皮損發病部位、年齡、季節不難診斷。同時作膿汁培養及藥敏試驗輔助診斷和治療。
併發症
膿皰病出現的併發症有:淋巴管炎、淋巴結炎、急性腎炎、甚至敗血症等。
治療方法
 常規治療--青黴素
常規治療--青黴素治療及預防的關鍵是保持良好的衛生習慣及周圍環境的清潔。一旦發生感染,及時治療,可以控制病情並防止擴散。
1常規治療
即使家庭中只有一位成員患有膿皰病,所有的人也都應注意環境衛生。經常用毛巾和肥皂清洗,可治療輕型患者。如果膿皰在48小時內不緩解,或者病人是兒童,應去看醫生。為了防止傳染,打破傳染環節,醫生會給全家人包括患者在內開抗菌浴液。
治療普通膿皰病,局部套用百多邦軟膏,非常有效,這是一種處方藥。不要使用那些非處方抗菌軟膏,他們效力太弱.以致不熊殺死葡萄球菌苗和鏈球苗,如不認真使用,會促進膿皰病的擴散。如果百多邦在48小時內無效,可向你的醫生要求開一些口服抗生素,如青毒素或紅黴素。青黴素注射可以預防嚴重的感染併發症,縮短癒合時間,並減少復發的機會。
2輔助治療
作為一種淺表的細菌感染,膿皰病各種輔助治療方法有效,特別是各種草藥軟膏。但使用時應小心,注意可能出現的各種刺激症狀,如果膿皰在12-24小時內仍未緩解,應去醫生處就診。
另一建議使用的草藥是沒藥。將5-10滴酊劑滴於患處,每日3次。茶樹油已經證實具有抗微生物的作用,將其塗於患處,可緩解瘙癢並且可促進癒合。
家庭治療
1如果你僅是有幾個小的膿瘡,可以簡單地通過經常使用肥皂和溫水清洗治療,也可使用以上治療方法,並且將患處暴露在空氣中,可減輕瘙癢。嚴重病例可用藥皂清洗感染部位,並且用適當的藥物進行治療。
2家庭中如果有膿皰病患者,每個家庭成員都應各自使用於淨的毛巾洗澡,避兔交叉感染。
 三黃丸
三黃丸中藥治療
1.皮膚紅斑或丘疹、膿皰、流黃水、結黃痂、焮熱疼痛。宜用銀花、連翹、梔子、黃芩、黃柏、萆薢、蒼朮、苡仁、黃連、甘草水煎服。
3.紫草油外搽。
4.青黛散,以植物油調敷。
5.用九一丹或紅油膏蓋貼。敷藥前先將膿皰挑破,分開包紮。
中醫辨證
分為熱毒和濕熱兩型。
1.熱毒型:夏季發病,肌膚水皰或膿皰,四周繞以紅暈,膿皰潰破溢膿,結痂,鄰近淋巴結腫痛,伴發熱,溲赤便乾,口渴,舌紅苔黃,脈數等。治宜:清熱解毒。可用:犀角化毒丸、五福化毒丸等。
2.濕熱型:夏秋季發病,肌膚水皰、大皰,四周紅暈,皰破脂水淋漓,浸淫成片,癢痛相兼,或見發熱,口渴,浸淫成片,納呆,舌苔黃膩,脈濡數。治宜:清化濕熱。可用:龍膽瀉肝丸、當歸龍薈丸等。常用西藥1.內服西藥症狀較嚴重、有全身症狀或有合併症者可選用。①複方新諾明:成人口服每次2片,每口2次,兒童酌減。對磺胺過敏者和孕婦禁用。②紅黴素:成人口服250毫克,每日4次,兒童口服125毫克,每日4次,療程10天。2.外用西藥①新黴素軟膏:塗敷患部,每日1-2次。②雷夫奴爾糊膏或軟膏:塗敷患部,每日1-2次。每次外用藥前均應清潔患部,常用的清洗藥有:0.1的雷夫奴爾液、1:8000的高錳酸鉀液、3%硼酸溶液、3%過氧化氫等,均可選用。若局部滲濕糜爛時可用雷夫奴爾或高錳酸鉀液濕敷。
 慶大黴素
慶大黴素西藥治療
1.輕者無需用抗生不。重者只要肌肉注射青黴素即可。另外,慶大黴素、紅黴素、磺胺類藥也可選用。
2.對伴有發熱、淋巴結腫大及淋巴管炎、皮疹廣泛、嬰兒、體弱兒童或長期外用藥無效者給予磺胺類抗生素,重症者最好膿液培養及藥敏試驗,以選擇有效的抗生素。新生兒膿皰病應按嚴重感染處理。
3.皰壁未破者可外搽1%樟腦、5%硫黃、爐甘石洗劑,每日搽多次。如膿皰較大,可用消毒針刺破皰壁,用乾淨棉球吸乾膿液,然後塗上藥物。膿皰已結痂,應以消毒液如0.5%新黴素溶液、0.1%雷凡諾爾液、或1:5000高錳酸鉀溶液清潔創面,除去痂皮,粘著較厚的不要強行剝離。然後外塗0.5%新黴素軟膏、百多邦軟膏,亦可用2%龍膽紫溶液。如創面滲液多的可用0.1%黃連素溶液顯敷。
食物治療
1.陳醋120克,豬苦膽1個,先將醋熬10分鐘,再放入豬膽汁熬成膏狀,取出放涼,洗淨患處後塗上此膏,每日1~2次。
2.鮮絲瓜葉適量,洗淨擰汁塗患處。
3.蠶豆莢燒灰,用菜油調後敷患處。
名家妙方
 核桃殼
核桃殼1.水八角適量。水煎,外洗,再研粉外敷患處。
2.馬蹄燒存性,研細面,塗於患處。
3.蠶豆殼、黃丹、香油各適量。將蠶豆殼在瓦上焙乾,研末,加黃丹少許,以香油調敷患處,乾則再敷,3日即愈。
4.黃瓜藤(陰乾,火焙存性)、枯礬。為細末,搽瘡上。
5.苦杏核2個,將其放火上燒著,待外殼黑焦後,剝去已成灰的外殼,取仁研末,用香油或其他植物油調塗患處。每日2~3次。
7.核桃殼數個,黃柏、枯礬各等量,陳醋適量。先將核桃殼用微火焙焦,與黃柏、枯礬共研細末,加陳醋調成糊狀備用。先用1:1000高錳酸鉀溶液洗淨患部皮膚,擦乾。有膿皰病者用針頭刺破膿皰,用消毒棉球拭淨黃水及膿液,將上藥敷上,暴露。重者1日2次,輕者1日1次。
8.魚腥草15克,黃柏、白蘚皮各9克。加水適量,煎取藥液,晾至室溫時外洗患處。每日3~4次。
9.用經霜後絲瓜根,炙灰,用麻油敷,即愈。
10.黑驢糞,燒存性,為末。香油調搽,試過神效。
11.用生石灰100克,硫磺250克研末,加水1250毫升,以文火煎24小時,煎到1000毫升,靜置,取清液洗患處。
13.綠豆粉、天花粉各30克,生甘草9克,共研細末。每次用10克,加蜂蜜及涼開水吞服。
14.鮮燈籠草、鮮馬齒莧各適量,洗淨搗爛取汁外搽。
15.黃連、黃柏、黃芩各30克,苦參30克,蛇床子15克,上藥加水1600毫升,煎取1200毫升藥液。濾過去渣冷卻後外洗患處,每日3次,每次外洗10分鐘,無論有無病灶,全身各部位均套用藥液洗擦,以防病灶擴散。
16.地膚子、黃柏各30克,芒硝50克,上藥共研細末,過篩,裝瓶備用。先用地膚子20克煎水洗淨患處,然後撒上藥末,每日2次。一般敷藥2~3天后,分泌物逐漸減少,5天左右,可結痂痊癒。
宜與忌
 西瓜
西瓜2.抓緊時間持續治療,防止蔓延擴散,力戎用手指搔抓。
3.常洗澡勤換衣,保持皮膚清潔。
4.頑固性膿皰病應去醫院治療。
5.有皮膚病(如痱子、夏季皮炎、濕疹等)者要及時治療,避免因搔抓而傳染上膿皰病。
6夏日要避暑,防曬,經常飲用清熱解暑之物,如夏桑菊、五花茶、西瓜、菊花、豆豆水或冬瓜、荷葉等。
7.小兒患膿皰病後,容易繼發急性腎炎。故應引起重視。
